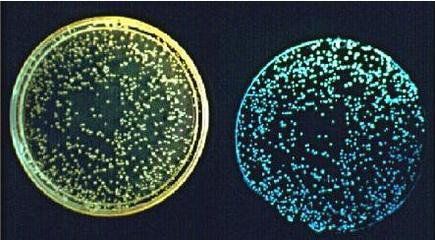
雨少了，水咸了，养虾的你必须关注水体发光，及时处理

昨日寒露,全国大部地区天气将由凉爽向寒冷过渡。对于水产养殖业气候是主导影响因素,气候季节转换,养殖工作会随着气候的变化迎来新的挑战。10月中旬之后,气候转凉,降水大量减少,海水盐度也有所上升,而外塘由于没有足够的淡水补充,池水的盐度也会有所变化。从而导致池塘很多理性指标的变化,而根据以往的经验,下半年池塘水体发光的现象比较常见,希望各位养殖户仔细观察,及早预防。

目前池塘水体发光,比较权威、有实验依据的说法有两个,一个是月光藻,另一个就是发光弧菌。
1
夜光藻
存在夜光藻的池塘,夜晚看料台,虾体会显得非常红,这种红在游泳足步足上有点深红的感觉。池塘有夜光藻会影响对虾的生长。
A 预防:
预防关键就是别让夜光藻大量繁殖。
原则非常简单:把是水调清爽,降低水体的腐败物和细菌总数,让夜光藻不能大量繁殖。
B 治理
a) 在夜光藻非常多的时候,也有人尝试有杀藻的方法,比如用扑草净等等先杀了夜光藻,几小时后泼洒塘生态对付夜光藻死亡后产生的硫化氢。
b) 也有养殖户采取连续几天泼洒塘生态后排水。具体应该怎么做好,最好结合你池塘的条件操作。
c)对于藻类通常会使用硫酸铜等来杀藻,虽然硫酸铜对杀灭藻类有比较好的效果,但对虾也会有些影响,杀完藻之后要用有机酸解毒,然后再加入藻种和培藻膏重新来进行肥水培藻。而因夜光藻发造成的红体也会随对虾蜕壳而消失。

3:夜光藻的危害
A 夜光藻本身并没有什么毒素,池塘里有大量的夜光藻时,夜光藻会粘附于虾的鳃上,阻碍了虾的呼吸并导致虾类窒息死亡。
B 夜光藻死亡分解过程中所产生的尸碱和硫化氢,直接干扰对虾的生理代谢。处理夜光藻时候,泼洒塘生态的目的就在于:是降低水体硫化氢的含量!
2
发光弧菌
对虾发光弧菌病“是由发光弧菌感染虾体产生的疾病,目前有哈维氏弧菌、美丽弧菌生物型I、费氏弧菌、火神弧菌和东方弧菌。”发光弧菌引起的水体发光:通常发生在成虾养殖的中后期。观察到的现象是:水体均匀发光、不会有点点荧光。严重的时候也会感染虾,引起虾体也发光。
1:发光弧菌引起水体发光的特点:
A 发光弧菌最适NaCl浓度为2~3 %。盐度在千分之20~30的时候比较多。养殖户使用加淡水作为首选的治理发光弧菌引起的水体发光手段,的的确确有理论依据。
B 发光弧菌的发光强度与发光弧菌的密度有很大的相关性。当水体的发光弧菌在低密度时,水体是几乎测不到发光的。而当发光弧菌密度达到一定数值以后,发光强度会突发式增强。
C 突发性。
池塘是碳、氮不断的在升高或者保持着比较高的碳、氮,有一些养殖户还怕发光弧菌饿着,天天泼洒葡萄糖,让这些弧菌衣食无忧的繁殖。当发光弧菌密度达到一定数值以后,发光强度则突发式增强!你没有关注而已。

3:发光弧菌的治理
处理原则就是消毒(降低水体的细菌总数)+抗菌素(治疗对虾的感染)。要关注是:
A 水体减肥(瘦水)后再使用消毒药,为水体减肥是消毒药效果的保证。避免这里消毒杀菌哪里细菌大吃大喝拼命繁殖,刚刚杀了弧菌,弧菌就马上繁殖再升高的现象。
B 拌喂抗菌素。
C 对于弧菌,笔者个人的看法是以菌治菌,用蛭弧菌来抑制弧菌使水体中的弧菌数保持在较低水平。

发光藻类和发光弧菌都会引起水体发光,但是处理方法却又很大的区别,作为养殖户应该要关注区分,找准发光的原因,对症下药才能永绝后患。
3
区分
如何辨别发光藻类和发光弧菌的辨别:一般情况下,如果是发光藻类用手搅动养殖水体是点点发光,虾在水中游可看到发光;如果是发光弧菌用手搅水是一片发光,晚上部分死虾可见发光。
哈维氏弧菌感染的症状,死虾在夜间会发光,值得关注的是这种发光不是在体表的发光,而是在虾体肌肉内的发光!因为虫和藻可能会附着在虾的体表,而造成错误的判断。被“发光弧菌病”的感染的对虾会表现为摄食量减少,活力减弱,但是随着发弧菌对虾体的感染加剧,基本停食,甚至有一段时间对虾应激很大,在养殖水体中上串下跳,并且从虾体外观上可以用肉眼直接观察到发光弧菌感染的病灶,眼部、尾部、鳃、躯干部及游泳足都会不停程度感染发光,在黑夜中基本可以看到一只“荧光虾”。这些躯干和器官会先后出现不同程度坏死、溃烂、掉尾、肌肉白浊等现象,如果把出现黑色的坏死、溃烂、粘连的部位放到载玻片上压碎进行镜检,可以见到大量的弧菌,甚至在体液中也可发现大量发光弧菌。无论感染哪一部分,不及时治疗,一般48小时后将开始导致大量死亡。尤其在对虾育苗池中如果已经出现大量发光弧菌,检查的方法同前,可见到育苗池内有大量的荧光,时隐时现。有养殖户观察并总结到,水体发光,虾体也出现荧光,则已经可能已经感染对虾体内,这时治疗已相对比较困难。
发光甲藻(养殖户也有习惯叫夜光虫):一般发生在夏季高温时期有机质多,水太肥的池塘。观察到的现象是:发光藻晚上分布在水的上层,用手划一下水面到池水中点点荧光,有时增氧机打出的水花也能见到发光。

END